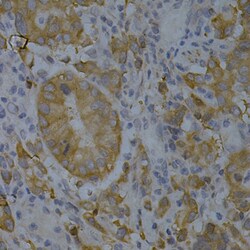
Invitrogen BIN1 Polyclonal Antibody 100 &mu;L; Unconjugated:Antibodies,

Learn More
Invitrogen™ BIN1 Polyclonal Antibody
Rabbit Polyclonal Antibody
Brand: Invitrogen™ PA595932
Description
Immunogen sequence: QNLNDVLVGL EKQHGSNTFT VKAQPSDNAP AKGNKSPSPP DGSPAATPEI RVNHEPEPAG GATPGATLPK SPSQSSLPAV VVETFPATVN GTVEGGSGAG RLDLPPGFMF KVQAQHDYTA TDTDELQLKA GDVVLVIPFQ NPEEQDEGWL MGVKESDWNQ HKELEKCRGV FPENFTERVP; Positive Samples: SW620; Cellular Location: Cytoplasm, Nucleus.
This gene encodes several isoforms of a nucleocytoplasmic adaptor protein, one of which was initially identified as a MYC-interacting protein with features of a tumor suppressor. Isoforms that are expressed in the central nervous system may be involved in synaptic vesicle endocytosis and may interact with dynamin, synaptojanin, endophilin, and clathrin. Isoforms that are expressed in muscle and ubiquitously expressed isoforms localize to the cytoplasm and nucleus and activate a caspase-independent apoptotic process. Studies in mouse suggest that this gene plays an important role in cardiac muscle development. Alternate splicing of the gene results in ten transcript variants encoding different isoforms. Aberrant splice variants expressed in tumor cell lines have also been described.
Specifications
| BIN1 | |
| Polyclonal | |
| Unconjugated | |
| BIN1 | |
| ALP-1; AMPH 2; Amph2; amphiphysin 2; amphiphysin II; amphiphysin IIamph2; amphiphysin-like; amphiphysin-like protein; AMPHL; Bin1; box dependant MYC interacting protein 1; box-dependent myc-interacting protein 1; BRAMP-2; bridging integrator 1; DKFZp547F068; MGC10367; MGC105358; myc box dependent interacting protein 1; myc box-dependent-interacting protein 1; SH3 domain-containing protein 9; SH3P9; similar to bridging integrator 1 isoform 9 | |
| Rabbit | |
| Affinity chromatography | |
| RUO | |
| 117028, 274 | |
| -20°C, Avoid Freeze/Thaw Cycles | |
| Liquid |
| ELISA, Immunohistochemistry (Paraffin), Western Blot, Immunocytochemistry | |
| 0.66 mg/mL | |
| PBS with 50% glycerol and 0.02% sodium azide; pH 7.3 | |
| O00499, O08839 | |
| BIN1 | |
| Recombinant fusion protein containing a sequence corresponding to amino acids 230-409 of human BIN1 (NP_6476011). | |
| 100 μL | |
| Primary | |
| Human, Rat | |
| Antibody | |
| IgG |
Your input is important to us. Please complete this form to provide feedback related to the content on this product.